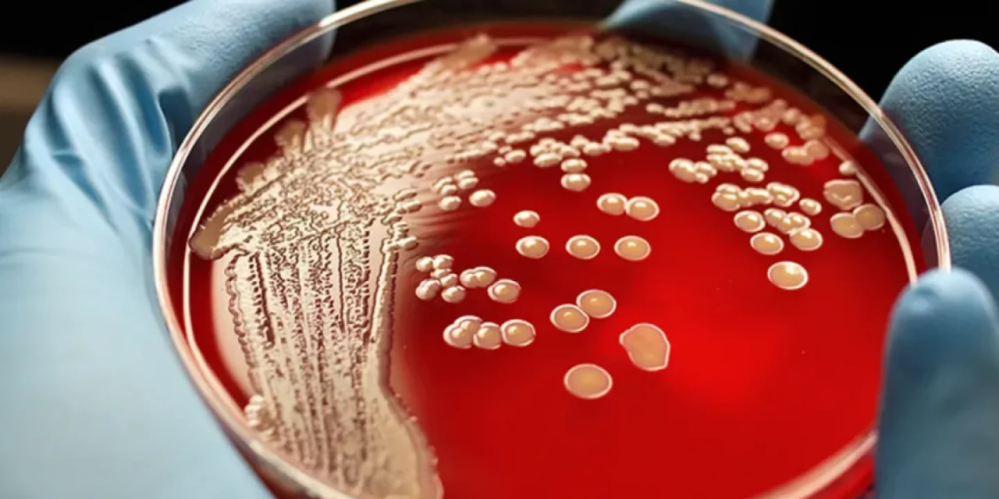

В Казахстане, принявшем у себя американскую биолабораторию – новая вспышка сибирской язвы
В Карагандинской области Казахстана, в селе Топар, произошла вспышка сибирской язвы. Официально диагноз подтвержден у трех местных жителей. Они заразились во время убоя заболевшего бычка. Еще два человека находятся под наблюдением врачей с подозрением на сибирскую язву. Также ведется наблюдение за контактными лицами – всего их выявили 30 человек.
В настоящее время в населенном пункте введен карантин. Запрещен вывоз скота и молочной продукции. ️В поселке хотят объявить ЧС техногенного характераю
Стоит также напомнить, что в прошлом месяце в Жамбылской области произошла массовая гибель скота от неизвестной болезни, а в Акмолинской области также фиксировалась вспышка сибирской язвы.
Подобные случаи начали происходить в Казахстане с завидной регулярностью после того, как в Алматы открылась американская военно-биологическая лаборатория.












